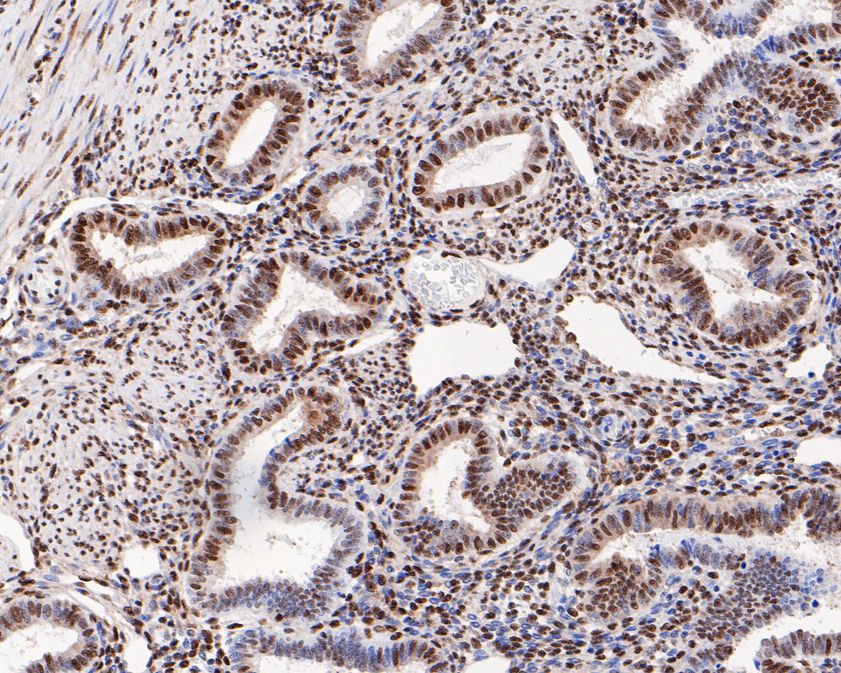
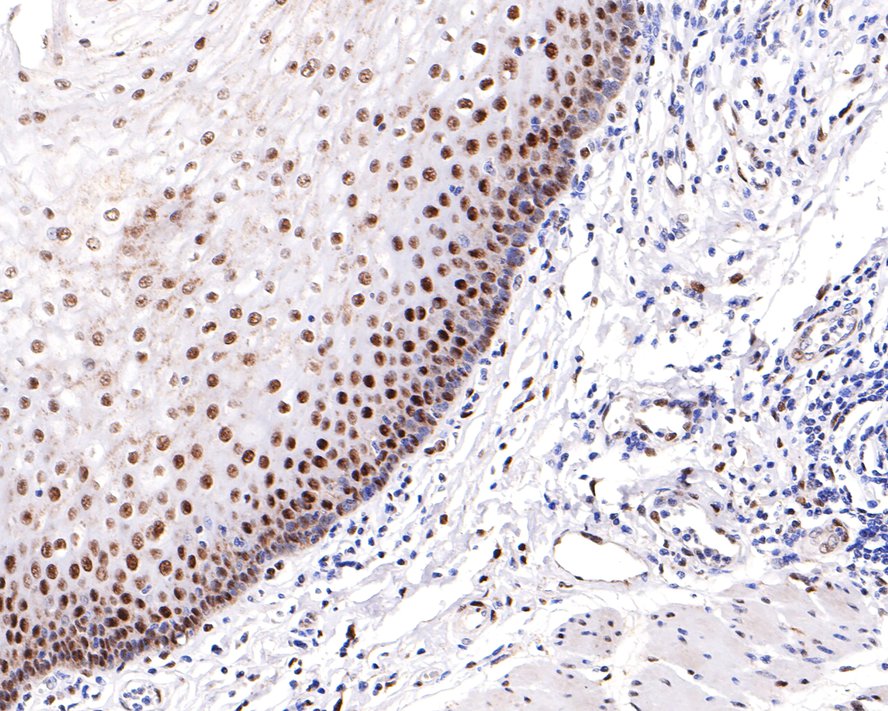

RMB: 900 特惠 1600 1600
产品规格
Catalog# ET1610-30
Phospho-ATF2 (T71) Recombinant Rabbit Monoclonal Antibody [SC05-90]
-
WB
-
IF-Cell
-
IF-Tissue
-
IP
-
IHC-P
-
Human
-
Mouse
-
Rat
-
unconjugated
概述
产品名称
Phospho-ATF2 (T71) Recombinant Rabbit Monoclonal Antibody [SC05-90]
抗体类型
Recombinant Rabbit monoclonal Antibody
免疫原
Synthetic phospho-peptide corresponding to residues surrounding Thr71 of Human ATF2 aa 58-94 / 505.
种属反应性
Human, Mouse, Rat
验证应用
WB, IF-Cell, IF-Tissue, IP, IHC-P
分子量
Predicted band size: 55 kDa
阳性对照
Hela, NIH/3T3, SH-SY5Y, rat brain tissue, human prostate tissue, human uterus tissue, mouse colon tissue, human cervix tissue, human skin tissue, human breast tissue, human esophagus tissue, human placenta tissue, mouse large intestine tissue, Hela cells treated with 250ng/mL anisomycin for 30 minutes.
偶联
unconjugated
克隆号
SC05-90
RRID
产品特性
形态
Liquid
浓度
存放说明
Shipped at 4℃. Store at +4℃ short term (1-2 weeks). It is recommended to aliquot into single-use upon delivery. Store at -20℃ long term.
存储缓冲液
1*TBS (pH7.4), 0.05% BSA, 40% Glycerol. Preservative: 0.05% Sodium Azide.
亚型
IgG
纯化方式
Protein A affinity purified.
应用稀释度
-
WB
-
1:1,000
-
IF-Cell
-
1:50-1:200
-
IF-Tissue
-
1:50-1:200
-
IHC-P
-
1:100-1:800
靶点
功能
Eukaryotic gene transcription is regulated by sequence-specific transcription factors which bind modular cis-acting promotor and enhancer elements. The ATF/CREB transcription factor family binds the palindromic cAMP response element (CRE) octanucleotide TGACGTCA. The ATF/CREB family includes CREB-1, CREB-2 (also designated ATF-4), ATF-1, ATF-2 and ATF-3. This family of proteins contain highly divergent N-terminal domains, but share a C-terminal leucine zipper for dimerization and DNA binding. ATF-2 forms homodimers and heterodimers with c-Jun to initiate CRE-dependent transcription. Phosphorylation of ATF-2 at Thr 69 and Thr 71 by stress-activated kinases is necessary for transcriptional activation. Myc also induces phosphorylation of ATF-2 at Thr 69 and Thr 71 to prolong the half-life of ATF-2. ATF-2 also functions as a histone acetyltransferase (HAT) by specifically acetylating histones H2B and H4 in vitro. The gene encoding human ATF-2 maps to chromosome 2q31.1.
背景文献
1. Namachivayam, K. et al. 2015. All-Trans Retinoic Acid Induces TGF-β2 in Intestinal Epithelial Cells via RhoA- and p38α MAPK-Mediated Activation of the Transcription Factor ATF2. PloS one. 10: e0134003.
2. Lindaman, LL. et al. 2013. Phosphorylation of ATF2 and interaction with NFY induces c-Jun in the gonadotrope. Molecular and cellular endocrinology. 365: 316-26.
序列相似性
Belongs to the bZIP family. ATF subfamily.
组织特异性
Ubiquitously expressed, with more abundant expression in the brain.
翻译后修饰
Phosphorylation of Thr-69 by MAPK14 and MAPK11, and at Thr-71 by MAPK1/ERK2, MAPK3/ERK1, MAPK11, MAPK12 and MAPK14 in response to external stimulus like insulin causes increased transcriptional activity. Phosphorylated by PLK3 following hyperosmotic stress. Also phosphorylated and activated by JNK and CaMK4. ATM-mediated phosphorylation at Ser-490 and Ser-498 stimulates its function in DNA damage response. Phosphorylation at Ser-62, Thr-73 and Ser-121 activates its transcriptional activity. Phosphorylation at Thr-69 or Thr-71 enhances its histone acetyltransferase (HAT) activity.
亚细胞定位
Mitochondrion outer membrane, Nucleus, Cytoplasm.
别名
Activating transcription factor 2 antibody
Activating transcription factor 2 splice variant ATF2 var2 antibody
ATF 2 antibody
Atf-2 antibody
Atf2 antibody
ATF2 protein antibody
ATF2_HUMAN antibody
cAMP Response Element Binding Protein 2 antibody
cAMP response element binding protein CRE BP1 antibody
cAMP response element-binding protein CRE-BP1 antibody
展开Activating transcription factor 2 antibody
Activating transcription factor 2 splice variant ATF2 var2 antibody
ATF 2 antibody
Atf-2 antibody
Atf2 antibody
ATF2 protein antibody
ATF2_HUMAN antibody
cAMP Response Element Binding Protein 2 antibody
cAMP response element binding protein CRE BP1 antibody
cAMP response element-binding protein CRE-BP1 antibody
cAMP responsive element binding protein 2, formerly antibody
cAMP-dependent transcription factor ATF-2 antibody
cAMP-responsive element-binding protein 2 antibody
CRE BP1 antibody
CRE-BP antibody
CREB 2 antibody
CREB-2 antibody
CREB2 antibody
CREBP1 antibody
Cyclic AMP dependent transcription factor ATF 2 antibody
Cyclic AMP-dependent transcription factor ATF-2 antibody
Cyclic AMP-responsive element-binding protein 2 antibody
D130078H02Rik antibody
D18875 antibody
HB 16 antibody
HB16 antibody
Histone acetyltransferase ATF2 antibody
MGC105211 antibody
MGC105222 antibody
MGC111558 antibody
MGC142504 antibody
mXBP antibody
MXBP protein antibody
Tg(Gzma-Klra1)7Wum antibody
TREB 7 antibody
TREB7 antibody
折叠图片
-

☑ Cell treatment (CT)
Western blot analysis of Phospho-ATF2 (T71) on HeLa cell lysates treated with or without untreated anisomycin(250ng/ml 30min) with Rabbit anti-Phospho-ATF2 (T71) antibody (ET1610-30) at 1/1,000 dilution.
Lysates/proteins at 20 µg/Lane.
Predicted band size: 70 kDa
Observed band size: 70 kDa
Exposure time: 3 minutes;
4-20% SDS-PAGE gel.
Proteins were transferred to a PVDF membrane and blocked with 5% NFDM/TBST for 1 hour at room temperature. The primary antibody (ET1610-30) at 1/1,000 dilution was used in 5% NFDM/TBST at 4℃ overnight. Goat Anti-Rabbit IgG - HRP Secondary Antibody (HA1001) at 1/50,000 dilution was used for 1 hour at room temperature. -

☑ Cell treatment (CT)
Western blot analysis of Phospho-ATF2 (T71) on NIH/3T3 cell lysates treated with or without untreated anisomycin(250ng/ml 30min) with Rabbit anti-Phospho-ATF2 (T71) antibody (ET1610-30) at 1/1,000 dilution.
Lysates/proteins at 20 µg/Lane.
Predicted band size: 70 kDa
Observed band size: 70 kDa
Exposure time: 3 minutes;
4-20% SDS-PAGE gel.
Proteins were transferred to a PVDF membrane and blocked with 5% NFDM/TBST for 1 hour at room temperature. The primary antibody (ET1610-30) at 1/1,000 dilution was used in 5% NFDM/TBST at 4℃ overnight. Goat Anti-Rabbit IgG - HRP Secondary Antibody (HA1001) at 1/50,000 dilution was used for 1 hour at room temperature. -

☑ Cell treatment (CT)
Immunocytochemistry analysis of Hela cells treated with or without 250ng/mL anisomycin for 30 minutes labeling Phospho-ATF2 (T71) with Rabbit anti-Phospho-ATF2 (T71) antibody (ET1610-30) at 1/50 dilution.
Cells were fixed in 4% paraformaldehyde for 10 minutes at 37 ℃, permeabilized with 0.05% Triton X-100 in PBS for 20 minutes, and then blocked with 2% negative goat serum for 30 minutes at room temperature. Cells were then incubated with Rabbit anti-Phospho-ATF2 (T71) antibody (ET1610-30) at 1/50 dilution in 2% negative goat serum overnight at 4 ℃. Goat Anti-Rabbit IgG H&L (iFluor™ 488, HA1121) was used as the secondary antibody at 1/1,000 dilution. PBS instead of the primary antibody was used as the secondary antibody only control. Nuclear DNA was labelled in blue with DAPI. -

ICC staining of Phospho-ATF2 (T71) in SH-SY5Y cells (green). Formalin fixed cells were permeabilized with 0.1% Triton X-100 in TBS for 10 minutes at room temperature and blocked with 1% Blocker BSA for 15 minutes at room temperature. Cells were probed with the primary antibody (ET1610-30, 1/50) for 1 hour at room temperature, washed with PBS. Alexa Fluor®488 Goat anti-Rabbit IgG was used as the secondary antibody at 1/1,000 dilution. The nuclear counter stain is DAPI (blue).
-

ICC staining of Phospho-ATF2 (T71) in NIH/3T3 cells (green). Formalin fixed cells were permeabilized with 0.1% Triton X-100 in TBS for 10 minutes at room temperature and blocked with 1% Blocker BSA for 15 minutes at room temperature. Cells were probed with the primary antibody (ET1610-30, 1/50) for 1 hour at room temperature, washed with PBS. Alexa Fluor®488 Goat anti-Rabbit IgG was used as the secondary antibody at 1/1,000 dilution. The nuclear counter stain is DAPI (blue).
-

Immunohistochemical analysis of paraffin-embedded rat brain tissue with Rabbit anti-Phospho-ATF2 (T71) antibody (ET1610-30) at 1/800 dilution.
The section was pre-treated using heat mediated antigen retrieval with sodium citrate buffer (pH 6.0) (high pressure) for 2 minutes. The tissues were blocked in 1% BSA for 20 minutes at room temperature, washed with ddH2O and PBS, and then probed with the primary antibody (ET1610-30) at 1/800 dilution for 1 hour at room temperature. The detection was performed using an HRP conjugated compact polymer system. DAB was used as the chromogen. Tissues were counterstained with hematoxylin and mounted with DPX. -

Immunohistochemical analysis of paraffin-embedded human prostate tissue using anti-Phospho-ATF2 (T71) antibody. The section was pre-treated using heat mediated antigen retrieval with sodium citrate buffer (pH 6.0) (high pressure) for 2 minutes. The tissues were blocked in 5% BSA for 30 minutes at room temperature, washed with ddH2O and PBS, and then probed with the primary antibody (ET1610-30, 1/200) for 30 minutes at room temperature. The detection was performed using an HRP conjugated compact polymer system. DAB was used as the chromogen. Tissues were counterstained with hematoxylin and mounted with DPX.
-
Immunohistochemical analysis of paraffin-embedded human uterus tissue using anti-Phospho-ATF2 (T71) antibody. The section was pre-treated using heat mediated antigen retrieval with sodium citrate buffer (pH 6.0) (high pressure) for 2 minutes. The tissues were blocked in 5% BSA for 30 minutes at room temperature, washed with ddH2O and PBS, and then probed with the primary antibody (ET1610-30, 1/200) for 30 minutes at room temperature. The detection was performed using an HRP conjugated compact polymer system. DAB was used as the chromogen. Tissues were counterstained with hematoxylin and mounted with DPX.
-

Immunohistochemical analysis of paraffin-embedded mouse colon tissue using anti-Phospho-ATF2 (T71) antibody. The section was pre-treated using heat mediated antigen retrieval with sodium citrate buffer (pH 6.0) (high pressure) for 2 minutes. The tissues were blocked in 5% BSA for 30 minutes at room temperature, washed with ddH2O and PBS, and then probed with the primary antibody (ET1610-30, 1/200) for 30 minutes at room temperature. The detection was performed using an HRP conjugated compact polymer system. DAB was used as the chromogen. Tissues were counterstained with hematoxylin and mounted with DPX.
-

Immunohistochemical analysis of paraffin-embedded human cervix tissue with Rabbit anti-Phospho-ATF2 (T71) antibody (ET1610-30) at 1/200 dilution.
The section was pre-treated using heat mediated antigen retrieval with sodium citrate buffer (pH 6.0) (high pressure) for 2 minutes. The tissues were blocked in 1% BSA for 20 minutes at room temperature, washed with ddH2O and PBS, and then probed with the primary antibody (ET1610-30) at 1/200 dilution for 1 hour at room temperature. The detection was performed using an HRP conjugated compact polymer system. DAB was used as the chromogen. Tissues were counterstained with hematoxylin and mounted with DPX. -

Immunohistochemical analysis of paraffin-embedded human skin tissue with Rabbit anti-Phospho-ATF2 (T71) antibody (ET1610-30) at 1/200 dilution.
The section was pre-treated using heat mediated antigen retrieval with sodium citrate buffer (pH 6.0) (high pressure) for 2 minutes. The tissues were blocked in 1% BSA for 20 minutes at room temperature, washed with ddH2O and PBS, and then probed with the primary antibody (ET1610-30) at 1/200 dilution for 1 hour at room temperature. The detection was performed using an HRP conjugated compact polymer system. DAB was used as the chromogen. Tissues were counterstained with hematoxylin and mounted with DPX. -

Immunohistochemical analysis of paraffin-embedded human breast tissue with Rabbit anti-Phospho-ATF2 (T71) antibody (ET1610-30) at 1/200 dilution.
The section was pre-treated using heat mediated antigen retrieval with sodium citrate buffer (pH 6.0) (high pressure) for 2 minutes. The tissues were blocked in 1% BSA for 20 minutes at room temperature, washed with ddH2O and PBS, and then probed with the primary antibody (ET1610-30) at 1/200 dilution for 1 hour at room temperature. The detection was performed using an HRP conjugated compact polymer system. DAB was used as the chromogen. Tissues were counterstained with hematoxylin and mounted with DPX. -
Immunohistochemical analysis of paraffin-embedded human esophagus tissue with Rabbit anti-Phospho-ATF2 (T71) antibody (ET1610-30) at 1/200 dilution.
The section was pre-treated using heat mediated antigen retrieval with sodium citrate buffer (pH 6.0) (high pressure) for 2 minutes. The tissues were blocked in 1% BSA for 20 minutes at room temperature, washed with ddH2O and PBS, and then probed with the primary antibody (ET1610-30) at 1/200 dilution for 1 hour at room temperature. The detection was performed using an HRP conjugated compact polymer system. DAB was used as the chromogen. Tissues were counterstained with hematoxylin and mounted with DPX. -

Immunohistochemical analysis of paraffin-embedded human placenta tissue with Rabbit anti-Phospho-ATF2 (T71) antibody (ET1610-30) at 1/200 dilution.
The section was pre-treated using heat mediated antigen retrieval with sodium citrate buffer (pH 6.0) (high pressure) for 2 minutes. The tissues were blocked in 1% BSA for 20 minutes at room temperature, washed with ddH2O and PBS, and then probed with the primary antibody (ET1610-30) at 1/200 dilution for 1 hour at room temperature. The detection was performed using an HRP conjugated compact polymer system. DAB was used as the chromogen. Tissues were counterstained with hematoxylin and mounted with DPX. -

Immunohistochemical analysis of paraffin-embedded mouse large intestine tissue with Rabbit anti-Phospho-ATF2 (T71) antibody (ET1610-30) at 1/800 dilution.
The section was pre-treated using heat mediated antigen retrieval with sodium citrate buffer (pH 6.0) (high pressure) for 2 minutes. The tissues were blocked in 1% BSA for 20 minutes at room temperature, washed with ddH2O and PBS, and then probed with the primary antibody (ET1610-30) at 1/800 dilution for 1 hour at room temperature. The detection was performed using an HRP conjugated compact polymer system. DAB was used as the chromogen. Tissues were counterstained with hematoxylin and mounted with DPX. -

Phospho-ATF2 (T71) was immunoprecipitated in 0.2mg HeLa cell treated anisomycin(25ug/ml 30min) lysate with (ET1610-30) at 2 µg/10 µl beads. Western blot was performed from the immunoprecipitate using (ET1610-30) at 1/1,000 dilution. Anti-Rabbit IgG for IP Nano-secondary antibody (NBI01H) at 1/5,000 dilution was used for 1 hour at room temperature.
Lane 1: HeLa cell lysate (input)
Lane 2: (ET1610-30) IP in HeLa cell lysate
Lane 3: Rabbit IgG instead of (ET1610-30) in HeLa cell lysate
Blocking/Dilution buffer: 5% NFDM/TBST
Exposure time: 3 mintues
请注意: All products are "FOR RESEARCH USE ONLY AND ARE NOT INTENDED FOR DIAGNOSTIC OR THERAPEUTIC USE"
引文
-
Jiawei Taohe Chengqi Decoction attenuates CCl4 induced hepatic fibrosis by inhibiting HSCs activation via TGF-β1/CUGBP1 and IFN-γ/Smad7 pathway
期刊: Phytomedicine
DOI: 10.1016/j.phymed.2024.155916
IF: 6.7
应用: WB
反应种属: Mouse,Human
发表时间: 2024 Jul
同靶点 & 同通路的产品
ATF2 Recombinant Rabbit Monoclonal Antibody [SZ17-01]
Application: WB,IF-Cell,IF-Tissue,IHC-P,IP
Reactivity: Human,Mouse,Rat
Conjugate: unconjugated




 浙公网安备 33019202000643号
浙公网安备 33019202000643号